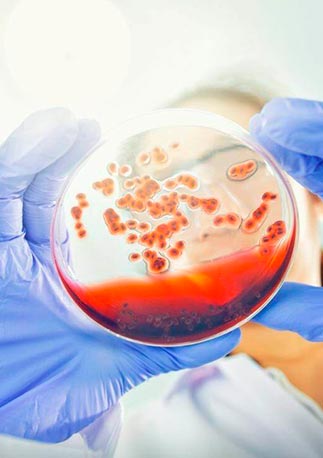
Image

Журнал
«ИНФЕКЦИЯ, ИММУНИТЕТ и ФАРМАКОЛОГИЯ»
Освешает доклинические испытания новых лекарственных форм и лекарственного растительного сырья, а также современные аспекты диагностики и лечение различных заболеваний.
Наука
Статьи и обзоры
В журнале «ИНФЕКЦИЯ, ИММУНИТЕТ и ФАРМАКОЛОГИЯ» публикуются научные статьи и обзоры, представляющие общий интерес для всей дисциплины в сфере инфекций, иммунологии и фармакологии.


